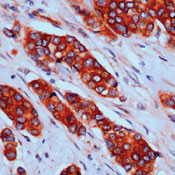
p130Cas Antibody in Immunohistochemistry (Paraffin) (IHC (P))

Search
Invitrogen
p130Cas Monoclonal Antibody (CAS-14 (35B-1A4))
{{$productOrderCtrl.translations['antibody.pdp.commerceCard.promotion.promotions']}}
{{$productOrderCtrl.translations['antibody.pdp.commerceCard.promotion.viewpromo']}}
{{$productOrderCtrl.translations['antibody.pdp.commerceCard.promotion.promocode']}}: {{promo.promoCode}} {{promo.promoTitle}} {{promo.promoDescription}}. {{$productOrderCtrl.translations['antibody.pdp.commerceCard.promotion.learnmore']}}
产品信息
MA5-14276
种属反应
已发表种属
宿主/亚型
分类
类型
克隆号
抗原
偶联物
形式
浓度
规格
纯化类型
保存液
内含物
保存条件
运输条件
RRID
产品详细信息
MA5-14276 targets p130Cas in IHC (P), IP, and WB applications and shows reactivity with Human and Rat samples.
The MA5-14276 immunogen is recombinant human p130Cas protein.
靶标信息
The p130Cas (Cas for Crk-associated substrate) is a common cellular target of phosphorylation signal via v-Crk and v-Src oncoproteins. p130Cas has a unique structure that contains a Src homology (SH)-3 domain followed by multiple YXXP motifs and a proline-rich regionp130Cas is implicated in a variety of biological processes including cell adhesion, cell migration, growth factor stimulation, cytokine receptor engagement and bacterial infection. Physiological functions of p130Cas include cardiovascular development, actin filament assembly and Src-induced cell transformation.
仅用于科研。不用于诊断过程。未经明确授权不得转售。
生物信息学
蛋白别名: BCA1; BCAR1, Cas family scaffold protein; BCAR1, Cas family scaffolding protein; Breast cancer anti-estrogen resistance protein 1; Cas scaffolding protein family member 1; CRK-associated substrate; Crk-associated substrate p130Cas; OTTHUMP00000174941; p130cas; p130Cas (pTyr410); p130Cas (pY410); p130Cas phospho; phospho p130Cas; unnamed protein product; v-crk-associated tyrosine kinase substrate
基因别名: BCAR1; CAS; CAS1; CASS1; CRKAS; P130CAS
UniProt ID: (Human) P56945, (Rat) Q63767
Entrez Gene ID: (Human) 9564, (Rat) 25414